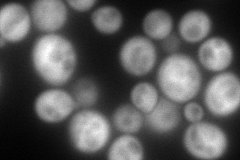
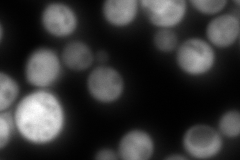

View description
ATPase involved in protein folding and nuclear localization signal (NLS)-directed nuclear transport; member of heat shock protein 70 (HSP70) family; forms a chaperone complex with Ydj1p; localized to the nucleus, cytoplasm, and cell wall
Localization:
Intensity:
Fold change:
Significance:
-
C’ GFP library in SD

below threshold18.27 -
N' NOP1pr-GFP in SD
cytosol251.515 -
N' TEF2pr-mCherry in SD

cytosol218.641 -
N' NATIVEpr-GFP in SD
cytosol587.543 -
N' TEF2pr-VC and Cyto-VN in SD

cytosol89.1573 -
C’ GFP library in SD+DTT

cytosol17.930.98No -
C’ GFP library in SD+H2O2

cytosol18.281No -
C’ GFP library in Starvation Media

cytosol18.781.02No -
C’ GFP library on the background of Pup2-DaMP

below threshold -
C’ GFP library on the background of CCT mutant

below threshold18.97041.03773No
